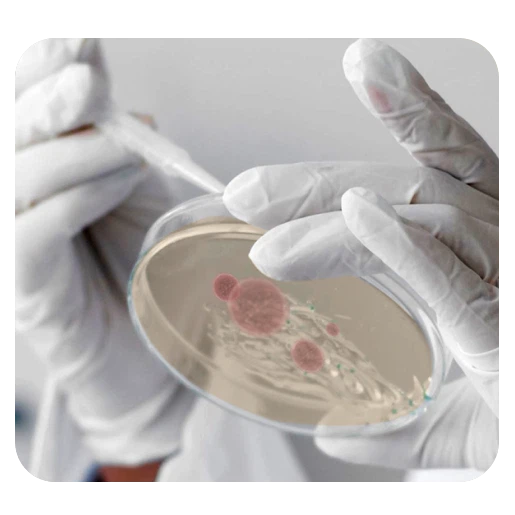
IMG

全球首創免校正酸鹼量測的方法,創新技術將電極量測原理整合在單一試片上。採用試片電極檢測pH值,具備以下特色:
Video

點擊影片開始加載








生物樣品例如血液,唾液,腦髓液,組織液等都無法大量採樣。通常這類量少的樣品需要購買價格昂貴的超小型的玻璃pH計電極才能完成測試。UH2可以在幾乎不破壞檢體和無需預處理的狀況下完成檢測。

活體(鱼血)檢測

體液(汗液)檢測
每一次使用只需從密封罐內取出全新的試片,且在測試後無需費時清洗保養。對於粘稠或容易吸附的樣品或配合各種特殊處理,突破傳統pH玻璃電極種種限制,提供您更多的應用。
可配合進行殺菌滅活等特殊處理

測試黏稠不易清理的樣品




| NIST standard pH buffer | 2 | 7 | 12 |
|---|---|---|---|
| Sampling number | 10 | 10 | 10 |
| AVG(pH) | 1.99 | 6.99 | 11.97 |
| SD(pH) | 0.01 | 0.02 | 0.03 |
| CV(%) | 0.75% | 0.35% | 0.26% |
| Accuracy Rrange(pH) | 0.05 | 0.08 | 0.09 |
| UH2 測量數值與NIST pH Buffer 比較 | |||||
|---|---|---|---|---|---|
| 量測範圍: | pH 0 - 14* | ||||
| 斜率: | 1.0029 | ||||
| 截距: | -0.0521 | ||||
| 相關係數(r): | 0.9999 | ||||
*pH 0 solution is 1.0 M HCl solution
pH 14 solution is 1.0 M NaOH solution SGS

線性關係
Linearity

精密度
Precision

準確度
Accuracy



蜂鳥探針在出廠前皆使用NIST 認證可追溯性標準品進行校正檢驗,並將批次校正資訊以QRcode模式結合在試片罐上,首次使用時只需將pH檢測儀掃描試片罐上QRcode後,即可直接進行pH量測。使⽤上不同於傳統pH玻璃電極,無需進行傳統繁雜的校正步驟。
測量方式1.於罐中取出酸鹼試片
測量方式1.
測量方式2.





Most Popular

適用於大部分的檢測需求
UH1 pH STRIPNew

適用於珍貴微量樣品
UH2 pH STRIPNew

適用於氣體
UH2-Gas pH STRIP



注意事項·:pH 試片電極應密封放置於試片罐中,使用時才取出以維持品質。每罐含25片酸鹼試片電極,每盒含2罐。
Subscribe us